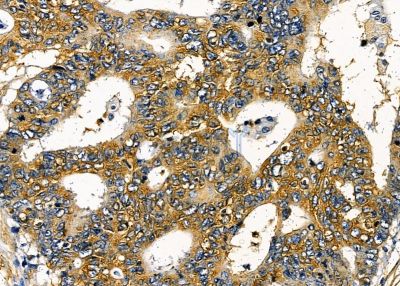
ILRL2 Antibody - DF8987 at 1/100 staining human liver cancer by IHC-P.

ILRL2 Antibody - #DF8987
| Product: | ILRL2 Antibody |
| Catalog: | DF8987 |
| Description: | Rabbit polyclonal antibody to ILRL2 |
| Application: | WB IHC IF/ICC |
| Cited expt.: | IF/ICC |
| Reactivity: | Human, Mouse |
| Mol.Wt.: | 65 kDa; 65kD(Calculated). |
| Uniprot: | Q9HB29 |
| RRID: | AB_2842183 |
Product Info
*The optimal dilutions should be determined by the end user. For optimal experimental results, antibody reuse is not recommended.
*Tips:
WB: For western blot detection of denatured protein samples. IHC: For immunohistochemical detection of paraffin sections (IHC-p) or frozen sections (IHC-f) of tissue samples. IF/ICC: For immunofluorescence detection of cell samples. ELISA(peptide): For ELISA detection of antigenic peptide.
Cite Format: Affinity Biosciences Cat# DF8987, RRID:AB_2842183.
Fold/Unfold
IL 1 receptor related protein 2; IL 1Rrp2; IL 36R; IL-1Rrp2; IL-36 receptor; IL1 receptor related protein 2; IL1R rp2; IL1R-rp2; Il1rl2; IL1RRP2; IL36R; ILRL2_HUMAN; Interleukin 1 receptor like 2; Interleukin 1 receptor related protein 2; Interleukin-1 receptor-like 2; Interleukin-1 receptor-related protein 2;
Immunogens
A synthesized peptide derived from human ILRL2, corresponding to a region within the internal amino acids.
Expressed in synovial fibroblasts and articular chondrocytes. Expressed in keratinocytes and monocyte-derived dendritic cells. Expressed in monocytes and myeloid dendritic cells; at protein level.
- Q9HB29 ILRL2_HUMAN:
- Protein BLAST With
- NCBI/
- ExPASy/
- Uniprot
MWSLLLCGLSIALPLSVTADGCKDIFMKNEILSASQPFAFNCTFPPITSGEVSVTWYKNSSKIPVSKIIQSRIHQDETWILFLPMEWGDSGVYQCVIKGRDSCHRIHVNLTVFEKHWCDTSIGGLPNLSDEYKQILHLGKDDSLTCHLHFPKSCVLGPIKWYKDCNEIKGERFTVLETRLLVSNVSAEDRGNYACQAILTHSGKQYEVLNGITVSITERAGYGGSVPKIIYPKNHSIEVQLGTTLIVDCNVTDTKDNTNLRCWRVNNTLVDDYYDESKRIREGVETHVSFREHNLYTVNITFLEVKMEDYGLPFMCHAGVSTAYIILQLPAPDFRAYLIGGLIALVAVAVSVVYIYNIFKIDIVLWYRSAFHSTETIVDGKLYDAYVLYPKPHKESQRHAVDALVLNILPEVLERQCGYKLFIFGRDEFPGQAVANVIDENVKLCRRLIVIVVPESLGFGLLKNLSEEQIAVYSALIQDGMKVILIELEKIEDYTVMPESIQYIKQKHGAIRWHGDFTEQSQCMKTKFWKTVRYHMPPRRCRPFPPVQLLQHTPCYRTAGPELGSRRKKCTLTTG
Research Backgrounds
Receptor for interleukin-36 (IL36A, IL36B and IL36G). After binding to interleukin-36 associates with the coreceptor IL1RAP to form the interleukin-36 receptor complex which mediates interleukin-36-dependent activation of NF-kappa-B, MAPK and other pathways (By similarity). The IL-36 signaling system is thought to be present in epithelial barriers and to take part in local inflammatory response; it is similar to the IL-1 system. Seems to be involved in skin inflammatory response by induction of the IL-23/IL-17/IL-22 pathway.
Membrane>Single-pass type I membrane protein.
Expressed in synovial fibroblasts and articular chondrocytes. Expressed in keratinocytes and monocyte-derived dendritic cells. Expressed in monocytes and myeloid dendritic cells; at protein level.
The TIR domain mediates NAD(+) hydrolase (NADase) activity. Self-association of TIR domains is required for NADase activity.
Belongs to the interleukin-1 receptor family.
References
Application: IF/ICC Species: Mouse Sample: lung tissue
Restrictive clause
Affinity Biosciences tests all products strictly. Citations are provided as a resource for additional applications that have not been validated by Affinity Biosciences. Please choose the appropriate format for each application and consult Materials and Methods sections for additional details about the use of any product in these publications.
For Research Use Only.
Not for use in diagnostic or therapeutic procedures. Not for resale. Not for distribution without written consent. Affinity Biosciences will not be held responsible for patent infringement or other violations that may occur with the use of our products. Affinity Biosciences, Affinity Biosciences Logo and all other trademarks are the property of Affinity Biosciences LTD.